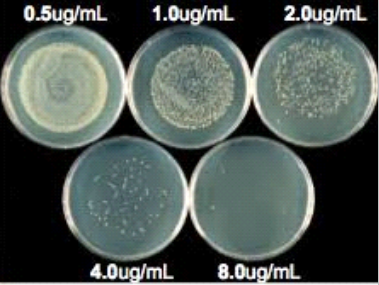
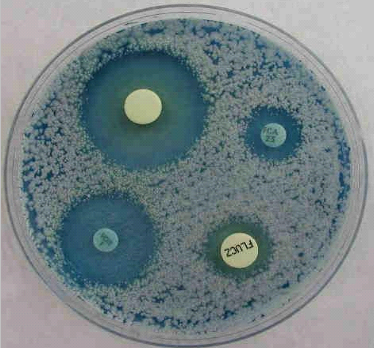

ARTICULO PARA COLEGAS
Género Candida: identificación y sensibilidad a los antifúngicos
Las infecciones causadas por levaduras del género Candida han aumentado de manera importante en las últimas décadas. Existen más de 190 especies pertenecientes al género y 10 de ellas son responsables de la mayorÃa de las infecciones fúngicas, siendo Candida albicans la especie más importante. Se encuentran en la naturaleza, en el suelo y agua dulce, vegetales, frutas, exudado de árboles, granos y en general toda sustancia rica en hidratos de carbono simples. Además, son habitantes habituales del aparato digestivo, respiratorio y regiones muco-cutáneas del ser humano y animales domésticos. El sistema gastrointestinal humano tiene una población pequeña pero constante de Candida albicans. En el adulto, dos factores regulan el número de levaduras en el intestino. El primero de ellos son otros miembros de la flora intestinal que ejercen un control sobre la densidad de población de las levaduras (principalmente lactobacilos y bacterias anaerobias) a través de factores antimicrobianos, inhibidores de la adherencia, potenciales de óxido-reducción y competencia por los nutrientes disponibles. El segundo factor, la dieta, en donde la ingestión excesiva de frutas frescas, dulces u otros materiales fermentables darán lugar a un aumento considerable en el número de levaduras intestinales, particularmente de Candida albicans.
En la década del 80, Candida albicans era la especie que causaba mayor número de infecciones fúngicas nosocomiales, seguida por otras especies no albicans. En los últimos años se han generado cambios epidemiológicos, entre los que destacan la aparición de cepas que han desarrollado resistencia secundaria a los antifúngicos y la sustitución de algunas especies susceptibles por otras con resistencia intrÃnseca.
Identificación
La identificación de la especie de toda levadura aislada en sangre o en cualquier otro lÃquido corporal estéril está plenamente justificada. También es conveniente la identificación de las levaduras de otras procedencias, sobre todo cuando ocurre de forma reiterada en diferentes muestras clÃnicas del mismo paciente, y siempre que se asuma que se trata de un organismo responsable de la patologÃa. La mayorÃa de los organismos levaduriformes crecen fácilmente en un gran número de medios de cultivo usados rutinariamente en el laboratorio de microbiologÃa (agar sangre, agar chocolate, agar CLDE, etc).
Identificación convencional.
Si se visualiza crecimiento en cualquier medio que sugiera posibilidad de levaduras, se realiza un examen en fresco al microscopio. Si en el mismo se observan levaduras, se procede a la identificación mediante subcultivo en un medio cromogénico, de los que hay varios comercializados. En el caso que no se trate de ninguna de las especies que este medio identifica, se procede a hacer la identificación mediante auxonograma de carbono preparado en el propio laboratorio, o mediante alguno de los métodos comerciales basados en él. La identificación bioquÃmica debe completarse con una identificación morfológica mediante un subcultivo al medio agar harina de maÃz con o sin Tween 80.
Medios comerciales basados en la asimilación de nutrientes.
Algunos de los más utilizados son:
- AUXACOLOR en la galerÃa Auxacolor (Bio-Rad) la asimilación se visualiza por el cambio de un indicador de pH.
- API 20 C AUX (bioMérieux): se compone de 20 cúpulas con sustratos deshidratados que permiten realizar 19 pruebas de asimilación. Las cúpulas se inoculan con un medio mÃnimo semisólido y las levaduras sólo se reproducen si son capaces de utilizar el sustrato correspondiente. Permite identificar un total de 34 especies diferentes. La lectura de estas reacciones se hace por comparación con un control de crecimiento y la identificación se obtiene, a partir de un código numérico, mediante un catálogo analÃtico o un programa informático.
- GalerÃa ID 32 C (bioMérieux): permite identificar 63 especies diferentes de organismos levaduriformes o relacionados y puede ser utilizada manualmente o bien de forma automatizada. La galerÃa se compone de 32 cúpulas: 29 contienen cada una un sustrato carbonado deshidratado, 1 es el control negativo, 1 detecta la sensibilidad a la cicloheximida y la última es una prueba colorimétrica para la esculina.
- Sistema Vitek 2 (bioMérieux) es un sistema totalmente automático para la detección del metabolismo fúngico que puede identificar levaduras y organismos afines en tan sólo 15 horas. Está basado en tecnologÃa de fluorescencia y se compone de las tarjetas de análisis con 63 pocillos, una consola satélite para la recogida de información, un módulo incubador, un módulo principal donde se procesa la información gracias a un software de análisis y un sistema experto avanzado. Permite la identificación de 51 especies diferentes y, al igual que los sistemas semiautomáticos, requiere pruebas adicionales (fundamentalmente morfológicas) en caso de baja discriminación.
- Rapid Yeast Identification Panel MicroScan (Dade Behring) es un método automatizado para la identificación rápida de 40 especies de levaduras y otros microorganismos afines. Se basa en la utilización de pruebas convencionales y cromogénicas en una placa de microdilución de 96 pocillos que utiliza 27 sustratos deshidratados.
- BD Phoenix (Becton Dickinson Diagnostic System) es también otra opción automatizada que puede ser útil en la identificación de levaduras de interés clÃnico. Detecta cambio colorimétrico del indicador redox como resultado del metabolismo celular y turbidimetrÃa como resultado de la división celular.
- Espectrometria de masas (MALDI-TOF) ha permitido la identificación de microorganismos mediante el análisis de proteÃnas, principalmente ribosomales, a través de la creación de un espectro de masas que es especÃfico para cada género y especie. Un espectrómetro de masas se compone de tres unidades funcionales, una fuente ionizante para transferir iones a las moléculas de la muestra en una fase gaseosa, un analizador de masas que separa los iones de acuerdo con su relación masa/carga y un dispositivo de detección para monitorizar los iones separados.

ROL DE LA EVALUACIÃN DE LA SENSIBILIDAD ANTIFÃNGICA
El estudio de la sensibilidad in vitro de Candida a los antifúngicos ofrece la posibilidad de contar con información al momento de seleccionar un antimicótico y elegir asà el más adecuado para el tratamiento.
Anteriormente se empleaban métodos no estandarizados de susceptibilidad a los antifúngicos, los cuales eran inconsistentes y muy poco reproducibles; esto debido a los múltiples factores que influyen en dichos ensayos, como el tamaño del inóculo, la composición y pH del medio, el formato de la prueba y la temperatura de incubación.
En 1992 se publicó en Estados Unidos el primer documento estándar internacional para susceptibilidad de levaduras elaborado por el National Committee for Clinical Laboratory Standards (NCCLS), actualmente Clinical Laboratory Standards Institute (CLSI) basado en un método de macrodilución en caldo (adaptado posteriormente a microdilución). Este documento (denominado M27-A) fue aprobado en 1997 para estudiar especies de Candida, hongos filamentosos y en determinados puntos de corte permite medir las concentraciones inhibitorias mÃnimas (CIM), definida como concentración mÃnima de un antimicótico, que inhibirá o reducirá el crecimiento de un moho o levadura in vitro de las principales especies de levaduras oportunistas (Candida spp, Cryptococcus neoformans) y hongos filamentosos (documento M38-A). Además, en los últimos años, se ha logrado estandarizar el método de difusión en agar en el documento M-44 del CLSI. Más recientemente, el European Committee on Antimicrobial Susceptibility Testing (EUCAST) ha aprobado metodologÃas de referencia para algunos compuestos antifúngicos. En comparación con la terapia antibacteriana, los tratamientos antifúngicos son limitados en cuanto a su eficacia y también son pocos los fármacos disponibles. Por otra parte, a diferencia de las bacterias, cuya resistencia emerge rápidamente, los hongos no se vuelven resistentes prontamente, debido a su largo tiempo de replicación.
En la actualidad, la emergencia de resistencia antimicótica se debe, principalmente, al reciente aumento de especies con resistencia natural y a la selección de cepas resistentes durante la terapia. Sin embargo, con el uso crónico de tratamientos antifúngicos, principalmente en pacientes inmunosuprimidos, se ha generado menor susceptibilidad y se ha establecido cierta resistencia a los azoles, por parte de algunos aislamientos. Asà también, el uso de azoles en medicina, agricultura y salud animal, ha producido una selección y diseminación de microorganismos resistentes.
Para enfrentar este reto es necesario entender los mecanismos de resistencia antifúngica, además de realizar el aislamiento microbiológico de los microorganismos patógenos, junto con pruebas de sensibilidad antifúngica.
MÃTODOS PARA LA EVALUACIÃN DE SENSIBILIDAD
Existen tres procedimientos generales para determinar la sensibilidad de los microorganismos a los antimicrobianos y estos son:
Dilución en caldo: Se procede a la dilución del antimicrobiano en una serie de tubos que contienen un caldo adecuado para el crecimiento del microorganismo que se va a ensayar. Se inocula el microorganismo, se incuba a una temperatura determinada y se determina la concentración del antimicrobiano que produce la inhibición del crecimiento del microorganismo.
Dilución en agar: Se procede a la dilución del antimicrobiano en un medio de cultivo apropiado y solidificado con agar. Se inoculan los microorganismos en la superficie del medio. Se incuba a una temperatura adecuada y se determina la concentración del antimicrobiano que produce la inhibición del crecimiento.
Difusión en agar con disco: Se inocula el microorganismo en la superficie del agar. Se deposita un disco con una concentración conocida de antimicrobiano. Se incuba a una temperatura adecuada. Se produce una zona de inhibición del crecimiento del microorganismo alrededor del disco. Dependiendo del tamaño de la zona, se puede determinar si el microorganismo es sensible, intermedio, indeterminado o resistente al antimicrobiano.
MÃTODOS COMERCIALES:
Etest
Automatizados
El método comercial cuyo formato se asemeja más a la metodologÃa del CLSI es el Sensitre® YeastOne (TREK Diagnostic Systems). Ha sido aprobado por la FDA y se basa en la microdilución en caldo, pero con un sustrato cromogénico para facilitar la interpretación de la CIM. Esta prueba ha sido investigada para la evaluación de la sensibilidad de Candida spp. a la anfotericina B, flucitosina, fluconazol, itraconazol, y más recientemente contra voriconazol, caspofungina y posaconazol, con buenos porcentajes de equivalencia cuando se compara con el estándar. Otro método disponible en es el Vitek 2® (Biomerieux), que es un método automatizado para determinar la CIM, utilizando una lectura espectrofotométrica. Tiene la ventaja de encontrarse acoplado a la identificación de levaduras y ha demostrado tener un alto nivel de reproductibilidad y equivalencia comparado con el CLSI. Además, los resultados pueden obtenerse a partir de las 10 hasta las 26 horas de incubación.


Limitaciones
La primera y fundamental limitación de cualquiera de las técnicas que se mencionaron más arriba es que el procedimiento se realiza en una atmósfera artificial que tiene poca relación con las complejas interacciones que ocurren entre el microorganismo y el hospedador. Asimismo, hay que tener en cuenta el tipo de hospedador (normal, inmunocomprometido por corticoides, por quimioterápicos, etc.) y el tipo de microorganismo que causa la infección (de crecimiento normal o lento, si necesita suplementos especiales para crecer, etc.). Por último, hay que considerar que en el laboratorio la concentración del antimicrobiano es constante y el inóculo del microorganismo también. En el hospedador, un número indeterminado de microorganismos (pequeño o grande) está expuesto a concentraciones fluctuantes del antimicrobiano entre cada dosis del mismo. En resumen, las condiciones in vivo difÃcilmente se pueden modificar y asà la evolución del paciente depende de un gran número de factores entre los que se encuentra la inherente sensibilidad del microorganismo a los antimicrobianos. En el laboratorio, se pueden manipular distintos elementos que influyen en los resultados de las pruebas de sensibilidad. Por tanto, es indispensable la estandarización de éstas para que, con independencia de donde se realicen los valores obtenidos resulten equiparables.
Indicaciones de los estudios de sensibilidad a los antifúngicos
No existen indicaciones estrictas para hacer estudios de sensibilidad y las recomendaciones se basan en opiniones de expertos, conferencias de consenso y estudios controlados con muestras reducidas. Algunos autores recomiendan realizar estudios de sensibilidad en:
- Estudios de vigilancia epidemiológica que permitan conocer los perfiles de susceptibilidad y resistencia de cepas clÃnicas, aisladas principalmente de infecciones invasoras en un paÃs o zona geográfica. De esta forma se pueden establecer cuáles son los tratamientos iniciales más adecuados o si se debe cambiar de tratamiento una vez que se ha identificado la especie (sensibilidad predecible).
- Todas las cepas que proceden de infecciones invasivas o de enfermos con algún tipo de inmunosupresión.
- Casos de fracaso terapéutico.
- Enfermos que han recibido profilaxis antifúngica previa.
- Casos en los que se ha aislado una especie poco frecuente, de la que se desconoce su espectro de sensibilidad in vitro o que presentan alta resistencia a los antifúngicos.
- Determinar el nivel de resistencia frente a nuevos compuestos con actividad antifúngica.
En estas situaciones, el estudio de sensibilidad puede ayudar a elegir el tratamiento más adecuado o incluso a variar la estrategia terapéutica especÃfica, aumentando la dosis del antifúngico, cambiando de fármaco o instaurando una terapia combinada.
BibliografÃa
- Zapata-González F, Cardona-Castro N. Lo que debemos saber sobre los métodos de sensibilidad a los antifúngicos. Rev CES Med 2012.
- CURSO A DISTANCIA Y TALLER: "determinación de la sensibilidad a los antifúngicos en el laboratorio" Departamento de MicologÃa INEI. ANLIS. Dr. Carlos G. Malbrán Buenos Aires, Argentina 2008.
- Diagnóstico microbiológico de las micosis y estudios de sensibilidad a los antifúngicos. Recomendaciones de la Sociedad Española de Enfermedades Infecciosas y MicrobiologÃa ClÃnica (SEIMC) 2006.
- Ortigoza-Medrano E, Arroyo-Espinosa D. Susceptibilidad in vitro de las especies de Candida a los antifúngicos en el Hospital de especialidades del Centro Médico nacional de occidente. Med Int Méx 2014.
- Zurita Macalupú S. Situación de la resistencia antifúngica de las especies del Género Candida en Perú. Rev Peru Med Exp Salud Pública 2018.
- Cuenca-Estrella M, Alastruey-Izquierdo A, Gómez-López A, Monzón A. Estudios de sensibilidad en levaduras. Actualización y novedades. Enferm Infecc Microbiol Clin. 2013.
Dra. Paola Rossi
Dto. MicrobiologÃa
IBC Instituto de BioquÃmica ClÃnica